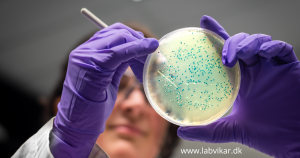

BESAT: Laborant-vikar søges til analysearbejde 10 timer om ugen i Ikast-Brande Kommune.
Der er tale om 5 timers arbejde om dagen i 2 dage om ugen med fleksibel placering af disse.
Laborantopgaverne består af analyser jf. kundens egenkontrolprogram: PCA, for totalkim, gær/skimmel og Koli med udsåning, aflæsning samt sensoriske tests etc.
Der vil være oplæring efter påske, den 7.+8. april, hvorefter kunden ønsker at vikaren kører vagten selv den 9. +10 april – og derfra 2 dage ugentligt i hver uge resten af april + hele maj.
Dertil hele uge 23 – og evt. mulighed for forlængelse derefter.
Har denne opgave fanget din interesse, så skynd dig at sende en mail til kunde@labvikar.dk med et par linjer om dine kompetencer for netop denne opgave (PCA, for totalkim, gær/skimmel og Koli med udsåning, aflæsning samt sensoriske tests etc.). Gå lige ind på på https://www.labvikar.dk/tjekliste/ og sikre dig, at du er fuldt oprettet.
Kun fuldt oprettede kandidater kommer i betragtning til vores opgaver.
LabVikar ApS
Avernakøvænget 4
5000 Odense C